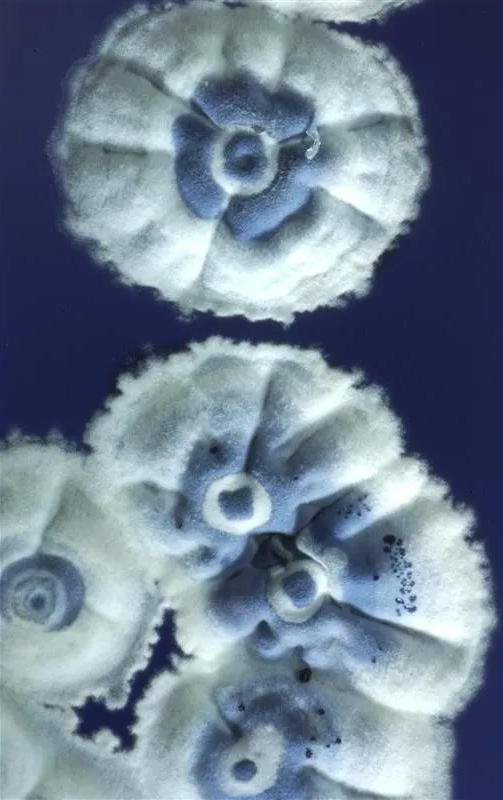
图片

四川宜宾,蜀南竹海。
在中国众多白酒产区中有这样一座城市,
它纵横三省、吞吐两江;
它因酒而兴,与酒同生;
它有2200年建城史,却有着4000年酿酒史,
它就是宜宾!


四川宜宾,三江口,岷江与金沙江汇流。
万里长江第一城的宜宾,素有“西南半壁”之称。
2021年白酒产量占四川省五分之一,营收更达到惊人的50%,妥妥的“川酒一哥”!

而在数千年酿酒历史长河中,宜宾从未缺席,堪称永不坠落的酒界明珠!
千年酒香浸润的宜宾,不仅诞生了浓香之王、川酒“六朵金花”之一的五粮液,还孕育出了叙府大曲、红楼梦酒、金喜来、金潭玉液等一众知名白酒品牌。
作为多粮浓香白酒发祥地,宜宾的度数着实有点儿高!



先有叙州酒,后有宜宾城,宜宾的酿酒史远超建城史。宜山宜水宜居之城的宜宾,不只是中国酒都,也是中国竹都,四川茶都。
堪称川酒界的“扛把子”,四川六大白酒产区之首的宜宾,究竟有何不同?
宜宾新天府,让所有原粮找到了最适宜生态位 昆明准静止锋,塑造了氤氲潮湿的宜宾小气候 背靠三条江,把大江大河出美酒发挥到了极致 传承七个世纪的窖泥,是时光赋予的珍贵礼物
(以下文字6500字,图片/图表40幅,时间跨度4000年,相对落差7000米,阅读需要15分钟)

宜宾酒品质密码,隐藏在“新天府粮仓”里!
得益于独特的气候,几乎所有酿酒原粮,都能在宜宾找到适合自己的最优生态位。

宜宾地处中亚热带湿润季风气候带,是全球同纬度地区水热资源匹配最好的地区之一。不仅年均降水量超过1000毫米,也是四川乃至全国冬暖中心之一,作物安全生长期超过200天(玉米生长期100-120天、高粱生长期一般为130-140天左右),无霜期超过330天。
高粱、大米、糯米、小麦、玉米,都能在这里恣意生长。而这些优质原粮,是开启宜宾多粮白酒酿造的物质基础。

酿酒高粱宜糯红7号是宜宾市农业科学院选育,该品种具有稳产性好、糯质、抗叶病、抗倒伏等优点,在宜宾广泛种植。
图为2022年3月18日,四川省宜宾市江安县四面山镇特色粮油现代农业园区,村民在搬运高粱苗。
摄影/严易程
经过无数代人探索与层层甄选,最终单宁、青花素等成分适量的宜宾糯红高粱;种皮较薄、吸水性强的川北弱筋小麦;富含矿物质、直链淀粉的川南原生水稻;植酸含量丰富的川南浅丘玉米;果实饱满、质地柔软的河谷糯稻最终脱颖而出,成为五种酿酒核心原粮。
而作为宜宾多粮酿造中占比最高的原粮(占比36%),宜宾糯红高粱对宜宾浓香型白酒特色风格的形成具有举足轻重的影响。
地处川南黔北的宜宾,是中国酿酒糯红高粱的最优产区之一,这里为酿酒高粱的恣意生长提供了绝佳的土壤。

四川宜宾,兴文县共乐镇五粮液酿酒专用粮基地。
这里由北向南依次为盆地浅丘、岭谷平原、中低山区地貌。而在海拔1000米以下紫色丘陵和低山下部,集中分布着中国最典型紫色土带,占到土壤总面积的43.8%,其中约2%为更稀有的酸紫黄泥土。
这些土壤多由侏罗纪、白垩纪紫色母岩发育而成,矿质养分丰富,富含有机质及磷、钾元素,沙、粘比例适当,微酸性至中性(pH4.5~6.5),保水供肥力好,非常适合酿酒高粱生长。

土壤与气候,共同成就了川派浓香道地原粮——宜宾糯红高粱,也让这种原产于非洲的“外来户”,在此大放异彩!

非洲高粱插画
原粮高品质的背后,有着近乎严苛的标准要求。
外在感官特征方面,宜宾糯红高粱穗型中散,穗大而籽粒丰硕,穗长35~50厘米,每穗3500~4500粒,粒卵圆形,千粒重15~17克,皮薄红润、颗粒饱满。
内在质量指标方面,粗淀粉含量≥60%,其中支链淀粉占粗淀粉含量的90%以上(支链淀粉含量/粗淀粉含量),蛋白质含量≥8.5%。

粳高粱与糯高粱切面对比。
摄影/Phil
宜宾糯红高粱同时具备“糯”(支链淀粉占90%以上)、“红”(单宁含量在1.2% - 2.0%之间)、“粉”(粉质淀粉占90%以上)三大特征。
正是在这种高标准下,才能产出宜宾白酒酿造的优质原粮。

四川宜宾,李庄白酒作坊里冒着热气的酒糟。
摄影/靖艾屏
2022年宜宾辖区内高粱种植面积达到27.6万亩,总产量8.5万吨,占四川省的1/3,成为四川省首屈一指的高粱主产区,为支撑宜宾千亿白酒产业提供了坚实物质基础。
宜宾糯红高粱,与这片土地上的其他酿酒原粮一起“集杂成醇”,成为解锁浓香的钥匙,共同开启“从一粒种子到一滴美酒”的神奇之旅!


大江大河出美酒,这一特征在宜宾身上体现的淋漓尽致!
金沙从雪岭而来,岷江经青衣而至,两江在宜宾携手后始称长江。这里是真正意义上的“长江零公里”!
江河为宜宾带来了两大优势:

酒品高下,结穴在水。
作为发酵过程中传递内部物质的介质的水,其酸碱度和所含成分既对微生物的生长和酶的活性有促进或抑制作用,又能与微生物代谢产物发生微妙化合反应,从而衍生出层次丰富多样的酒体风味和口感。
优质的水源,是酿酒另一个不可或缺的先决条件。

四川宜宾,竹海中的瀑布。
其实,古人很早就发现了这一点。北魏《齐民要术》强调:“初冻后,尽年暮,水脉即定,收水则用。”
地处江河上游的宜宾,占尽地利优势。岷江之水,更为宜宾酿酒提供了优质水源。作为长江第一大支流,岷江曾一度被认为是万里长江的源头。
岷江来自岷山深处的万年冰川融水。这些固体水库释放的涓涓细流,遍历高山深谷,从宽不盈米的清溪,一路穿云渡柳,期间或呼朋唤友,与黑水河、杂谷脑河等汇聚,滚滚而来。
最终在宜宾,与来自青藏高原的金沙江血脉融合,携手奔腾向海。

岷山群峰海拔多为3000米左右,分布着云杉、冷杉、落叶松组成的亚高山原始针叶林。针叶森间有灌木,灌木林下有苔藓地衣,地衣之下有松软的腐殖质层。它们层叠弥漫,擅长蓄水,构成滋养岷江的生命水库,守护着一方优质天赐水源。
四川省生态环境厅发布的《2020年四川省生态环境状况公报》显示,岷江水系总体水质优,干流13个断面(7个国考断面),优良水质断面达到100%。

据考证,唐代重碧春酒、北宋姚子雪曲酿造用水均来自戎州(今宜宾)的地下良泉——安乐泉。
优异品质引得无数文化名流纷纷为宜宾酒代言,其中就包括诗圣杜甫与“苏门四学士”之首的黄庭坚。

四川宜宾,流杯池公园,园内著名景点流杯池是黄庭坚根据王羲之《兰亭集序》的意境,利用天然石谷而建,距今已有900多年历史,是保存完好的宜宾古八景之一,也是现存最完好的酒文化发祥地之一。
杜甫在《宴戎州杨使君东楼》诗中,他写道:“重碧拈春酒,轻红擘荔枝”。当地的一杯重碧酒,让旅途劳顿中的杜甫诗兴大发。
黄庭坚饮“姚子雪曲”后写下《安乐泉颂》:“姚子雪曲,杯色争玉。得汤郁郁,白云生谷。清而不薄,厚而不浊。甘而不哕(yuě),辛而不螫。”

可见,优质水源为酒香增色不少,也验证了安乐泉是酿酒的上佳水源。
安乐泉,正是岷江故河道地下优质天然矿泉。

川酒甲天下,精华在宜宾。宜宾白酒长期“霸榜”背后,气候功不可没!
高大山脉围合而成的四川盆地虽然远离海洋,却成为我国最大的“温带海洋性气候”区,也让群山拱戴的天府之国,成为世界最大的“天然窖池”。

而在这座酵池边缘,分布着一系列浓香白酒产区,他们共同构成了全球惟一的“白酒U形酿酒带”。
宜宾,处在这条U型酿酒带的最底部,也是川酒所有产区中最偏南、最独特的一环。

这里处于青藏高原、云贵高原、四川盆地三大地理板块交界带,造就了宜宾无可比拟的地形多样性,成为整个四川地理多样性最突出的地区之一。
宜宾地形整体呈西南高、东北低态势,海拔垂直落差超过1700米,山地丘陵占比超过90%。
不仅如此,金沙江、岷江及其他数百条大小支流,不断下切形成深谷,与高耸的山川一起,雕凿了这里山地、丘陵、平坝、河谷相间的复杂地貌。

四川宜宾,蜀南竹海。
复杂而立体的地形,造就了立体的气候。
四季温差小、昼夜温差小,全年平均气温在17.9摄氏度,无霜期长达340多天。
山脉高差远远超过抬升气流冷却成雨的高度(雨云属于低云层,通常位于0.1-2.5公里高),让这里多地形雨,年降水量达1200毫米,气候湿润多云雾。


平行山脉、河谷相间的地形,让宜宾内部气流不畅,造成高静风频率和异常稳定的大气环境。
气流异常稳定的宜宾,少大风甚至无风,多平流雾。

气候与地形携手,给宜宾送来了另一个大礼包——昆明准静止锋。
作为影响整个西南地区的重要天气系统,每年的11月至次年4月,冷暖气团在这里相遇且势均力敌,于宜宾-兴仁-广南一线形成一条横跨超过700公里的巨大锋面,宛如一道“云墙”,让置身两侧的城市气温、日照、风、相对湿度环境迥然不同。
位于“云墙”北侧宜宾,常出现冬春季气温偏低、阴雨连绵的现象。

最终,气候与地形“天作之合”,携手在这片地理上的“死角”,共同造就了“宜宾酿酒小气候”!
这让作拥川贵核心区的宜宾,年平均相对湿度是中国白酒产区中最高的,在白酒主产季更为显著,比华北高近30%,比江淮产区高15%,给酿酒微生物生长营造了十分有利的空气湿度条件。
这里也被联合国教科文组织与世界粮农组织定义为“在地球同纬度上最适合酿造优质纯正蒸馏白酒的地区”。



拥有悠久酿造传承的宜宾,酿酒遗址中的老窖泥价值连城,地位堪比国宝“大熊猫”。
而这些窖泥,取材于四川盆地周边独有的弱酸性黄黏土。


这些浓香型白酒生产筑窖和喷窖的专用弱酸性黄黏土,富含硒、钙、钠、镁、磷、氮等矿物质和微量元素,能促进酿酒微生物群落生长繁衍,是酿酒微生物群落的“豪华摇篮”。
正是这些庞大微生物军团的辛勤劳作,创造出上千种满足美酒香味生成的醇、酸、酯、醛等物质,最终成就天府浓香经典。
此外,由黄黏土构筑的泥窖保水性强、黏性高,发酵过程中不仅隔绝空气进入酒窖,避免造成烧糟引起发酵异常,又可以防止酒窖中发酵生成的黄水渗漏到窖池外。
而这些黄水浑身是宝,其中含有一些未发酵完的淀粉和蛋白质,将黄水跟酒醅一起蒸馏过程中,释放出醇、醛、酯与酒醅串香,能显著增加白酒的香气,极大提升口感。

四川宜宾,当地酒厂实验室在检测酒质。
而黄水中含有的糖类、酸等,为藏身于窖泥之中的微生物繁殖提供营养。

六个半世纪以来,“以糟养窖,以窖养糟”的方式在泥窖四周反复交互上演,窖池中种类繁多的微生物和香味物质慢慢向窖泥深处渗透,成为酒体天然“香源”,且呈现时间越长,窖龄越久,微生物和香味物质越多越复杂,酿出的酒香味自然越浓的规律。

鳞次栉比的酿酒作坊,让宜宾有了“拔塞千家醉,开坛十里香”的盛况。
经历数个世纪时光打磨,每克古窖泥中含有超过10亿个微生物,让这些窖泥成为中国乃至世界上都绝无仅有酿酒瑰宝,堪称微生物黄金。
始建于1368年(明洪武元年)的五粮液长发升古窖池,距今已传承654年之久,也是目前我国现存最早的地穴式曲酒发酵窖池群。

2005年,取自五粮液古窖池的一块不起眼的“窖泥”,被中国国家博物馆永久收藏,成为引以为傲“国宝”。
更神奇的是,即使沉睡600年之久,窖泥中的微生物一旦进入适宜环境,随时可以“满血复活”,是名副其实的“活着的文物”。

窖池,好比一张泥巴做的大床,而发酵时还需要盖上一层厚厚的大棉被——封泥。
而这些封泥同样来自数千年演化而成的优质黄泥。
封泥富含铁、磷、镍、钴等多种元素,尤其是起固化作用的镍和起催化作用的钴,非常适宜酵母菌、己酸菌、乳酸菌、乙酸菌、丁酸菌等各种有益细菌集聚、生长、繁殖,最终形成庞大厌氧菌群,这些“看不见的功臣”昼夜不息的将宜宾的优质原粮变成浓香美酒。

宜宾,凭借4000年积淀,700年传承,最终将“中国白酒之都”揽入怀中!
自2017年实现营收突破1000亿元,成为中国第一个进入千亿的白酒产区后,作为“酒都”宜宾主营业务的白酒产业收入已经连续7年突破千亿。
2021年以1600亿营收,登顶白酒第一产区!

如今,宜宾白酒产业以不足全国同行业1/10的产量,支撑了全国近1/4的市场份额和近1/5的利润总额(2022年数据);以不足四川省同行业1/5的产量,支撑了一半的市场份额和近3/5的利润总额,在川酒界“独占鳌头”。
作为大国浓香世界级白酒产区,宜宾配得上“酒都”之冠称!

2022年12月17日,四川宜宾,2022中国国际名酒博览会现场的直播带货活动。2009年10月,中国轻工业联合会同意正式授予宜宾市“中国白酒之都”称号。
一枝独秀蜀山水,千种佳酿总宜宾。
喝五粮液,看四时景,听鸡鸣三省,观两江汇聚,醉一城风雅,也成为独属于宜宾这座城市的浪漫!
宜宾,以酒为媒,书写酒都历史,传承中国味道!


背靠三条江,喝酒当喝汤。来到宜宾,千万不要说自己能喝。
- END -
来源于公众号-国酒地理,本文略有删改。
